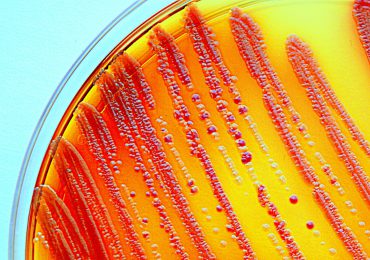
antibiotic resistant bacteria

The latest addition to the camera phone accessories marketplace lets you peer down at the microscopic world – no lab required.…
healthcare technology
Nanoparticles offer hope in the fight against antibiotic resistant bacteria
One of the biggest battles in science is taking place at the microscopic level as we race to find something to combat the rising numbers of antibiotic resistant bacteria.…
This ultra-thin wearable tech will help doctors look after patient health
The ongoing miniaturisation of semiconductors has enabled some big advances in wearable tech. The latest: a soft, stretchy, ultra thin sensor that can monitor patient vital signs.…
Biomedical engineering is seeing huge growth right now. Why?
Discussions about STEM usually revolve around a lack of women enrolments or declining interest overall. However, one discipline is bucking both trends: biomedical engineering.…
Ceramics might one day replace metal to help heal broken bones
Move over metal plates and screws – ceramic could become the go-to graft for mending broken bones.…
Could this student-designed nanotechnology help in the war against HIV?
A group of university students has brought us one step closer to a cure for HIV by developing an innovative DNA scaffold to study the virus at close range.…
What happens when you transform living cells into wearable tech?
Your next health check might come courtesy of this chic, discreet, 3D-printed ‘living tattoo’.…
This new algorithm could make for accident-free medical robots
A new algorithm could keep manufacturing, home care and medical robots from tripping over themselves and everything around them. …
A new startup wants to put ultrasound technology in every home
One engineer is borrowing techniques from the microelectronics industry to put ultrasound machines in every household. …
New superradiant nanodiamonds show a bright future for quantum tech
Australian scientists have, for the first time ever, created a super tiny, super shiny diamond – which is actually a pretty big deal for the future of quantum technology.…